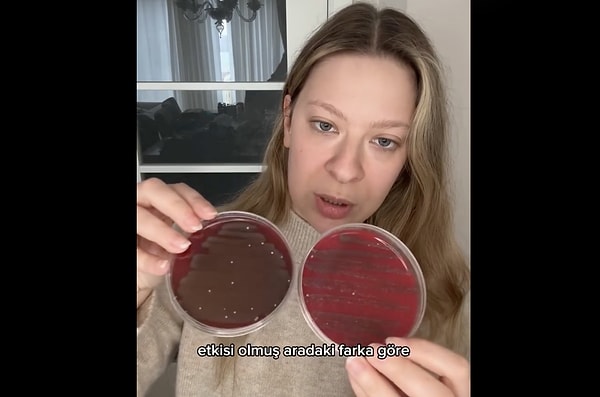
Peki karanfilin dişlere nasıl bir faydası var?

Karanfil ağız sağlığı için sıklıkla tavsiye ediliyor. Ağızdaki bakterileri öldürdüğü biliniyor. Eskilerin yemekten sonra ağza bir tane karanfil atma geleneği, sadece nezaket olsun diye değil, aslında asırlık bir hijyen alışkanlığına dayanıyor. Peki karanfil gerçekten bu kadar etkili mi?
Genetik Mühendisi Dilara Sarı, karanfilin bakterileri yok etmekteki gücünü bir deneyle ortaya koydu.
Peki karanfilin dişlere nasıl bir faydası var?
Doğal Antiseptik: İçindeki öjenol sayesinde ağız içindeki yaraların iyileşmesine yardımcı olur ve enfeksiyon riskini azaltır.
Diş Eti Dostu: Diş eti çekilmelerini ve kanamalarını önlemede destekleyicidir. Bazı doğal diş macunlarının karanfilli olmasının sebebi de tam olarak bu.
pH Dengesi: Ağız içindeki asit seviyesini dengeleyerek diş minesinin aşınmasını yavaşlatabilir.
Eğer karanfil çiğnemek tadı nedeniyle sert geliyorsa, birkaç karanfili sıcak suda bekleterek kendi doğal ağız gargaranızı da yapabilirsiniz. Hem alkolsüz hem de tamamen doğal bir temizlik sağlar.
Keşfet ile ziyaret ettiğin tüm kategorileri tek akışta gör!






Yorum Yazın